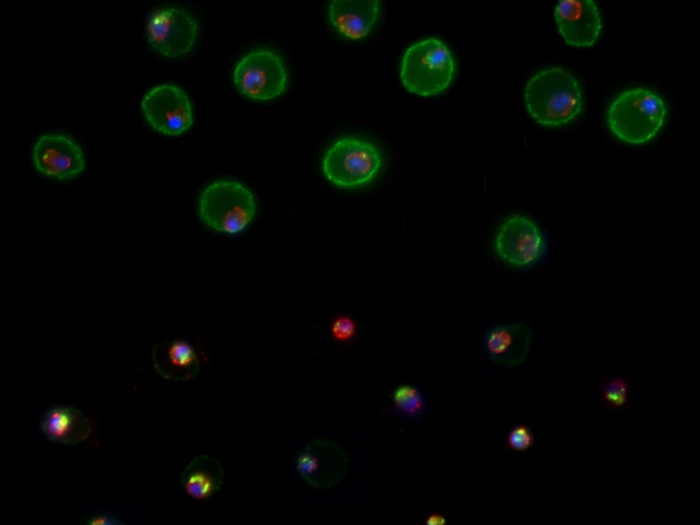

Discovering novel antimalarials to block parasite virulence
Drugs are the main weapons used to combat malaria infection, but parasites are becoming resistant and new medicines and drug targets are needed. One potential target is the protein trafficking pathways parasites and PTEX machine used to deliver proteins within their own cells and the human red blood cells the parasites infect. If the protein trafficking system could be blocked this would kill the parasites and eliminate malaria.
Objective
We aim to understand the biology underpinning malaria parasite virulence and use this knowledge to aid our discovery and development of novel antimalarials that reduce the parasites’ ability to harm its human host.
Approach
We perform a range of biochemical, cell biological and plate-based assays to understand basic parasite biology and virulence. We have developed a novel luminescence-based screening platform to discover novel antimalarials that target parasite components that are essential for parasite survival.
Community impact
Better, safer, and cheaper antimalarial drugs would benefit endemic communities around the world and could accelerate malaria elimination. The research will also provide new knowledge about parasite biology that could inform future treatment options.
Partners
Funding partners
National Health and Medical Research Council (NHMRC)
Collaborators
- Deakin University
- WEHI
- Deakin University
- Monash University
Project team

Professor Brendan Crabb AC
Director and CEO; Chair Australian Global Health Alliance and Chair Pacific Friends of Global Health

Associate Professor Paul Gilson
Deputy Discipline Head, Life Sciences; Co-Head Malaria Virulence, Drug Discovery and Resistance; Head of Burnet Cell Imaging Facility

Claudia Barnes
Research Assistant

Dr Hayley Bullen
Co-Head Malaria Virulence, Drug Discovery and Resistance




